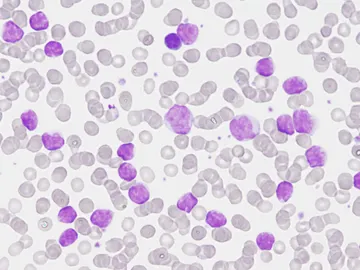

Astronomía, divulgación, descubrimientos, ecología, innovación...

Un nuevo test para la detección del cáncer de endometrio se puede realizar en casa

Casi la mitad de las muertes por cáncer en el mundo se deben a factores evitables
Completado el mapa genómico de la leucemia linfática crónica

Primer ensayo para evaluar si un suplemento alimenticio puede prevenir cáncer hereditario

Descubren un 'punto débil' que hace vulnerables a tumores resistentes a muchos fármacos

¿Ayudan las vitaminas a prevenir el cáncer o las enfermedades cardíacas? Un estudio niega estas propiedades

La metástasis del cáncer de mama avanza más durante la noche

Desarrollan un biomarcador que permitirá tratar de forma eficaz los cánceres más graves

Un mayor consumo de pescado puede estar asociado a un riesgo más alto de melanoma

Cáncer de mama: Un fármaco reduce las recaídas y aumenta la supervivencia

Microburbujas para combatir el cáncer

Madrid prueba un tratamiento en cáncer de páncreas para reducir el tumor antes de extirparlo

Cáncer de pulmón: Una nueva técnica elimina un tercio de los tumores antes de operarse

Hallada una vía para aumentar la eficacia de la radioterapia contra la metástasis cerebral
